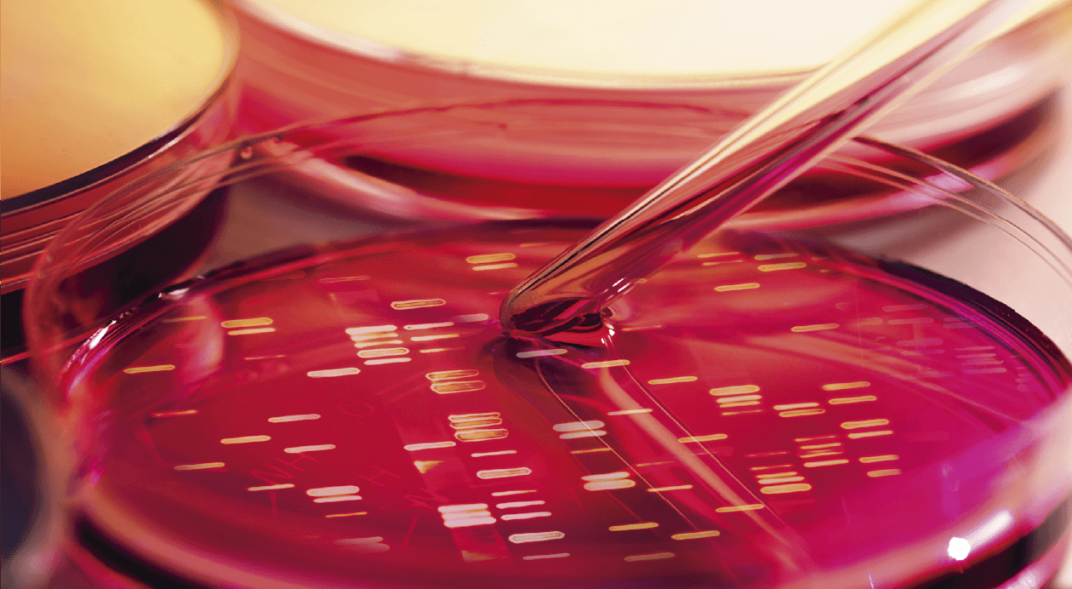
ADN

Hoy se dispone de una amplia gama de estudios que permiten conocer nuestro ADN e información genética. Desde Sanatorio Allende te contamos cuáles son los últimos test genéticos de diagnóstico que ponen a ciertas enfermedades bajo la lupa.
En la actualidad, es posible conocer la preciada información que posee nuestro ADN a través de test genéticos. Se trata de estudios bioquímicos que requieren sólo una extracción de sangre de una vena del brazo y que permiten analizar la información que se encuentra en el ADN de cada individuo. Si se descubre un error en nuestro material genético, es posible confirmar el diagnóstico de una enfermedad en estudio, o bien reconocer el riesgo de padecer una determinada patología.

El test genético es requerido por el médico cuando existe una sospecha de alguna enfermedad y sirve para seleccionar el tratamiento adecuado. (Sanatorio Allende)
Generalmente, el análisis genético está orientado a la detección de una enfermedad que el médico ya sospecha en función de ciertos signos y síntomas que el paciente manifiesta. Sin embargo, sin manifestar síntoma alguno es posible ser portador de una mutación genética que puede ser transmitida a nuestra descendencia.
Un test génico constituye un estudio diagnóstico que permite confirmar la sospecha clínica de una enfermedad o conocer el riesgo de padecerla, así como también seleccionar tratamientos y terapias adecuadas.
Además, el resultado arrojado por este test genético posibilitará asesorar al paciente y a su familia sobre las consecuencias de la alteración genética encontrada. El asesoramiento genético reviste gran importancia en cuanto a la prevención de enfermedades hereditarias, en muchas ocasiones, desconocidas por los miembros del grupo familiar.
Una enfermedad genética es aquella en la que existe un cambio, una variación o una mutación en la secuencia del ADN, producida en uno de nuestros genes. La mayoría de ellas son hereditarias, dado que las alteraciones en el ADN provienen de los padres y también pueden transmitirse a los hijos. Sin embargo, en algunos casos, los daños pueden originarse en el paciente y no provenir de sus progenitores, en este caso se tratará de una enfermedad genética no heredada. Todo test genético es solicitado por el profesional médico cuando existe una sospecha de alguna de estas enfermedades.
Los test genéticos no requieren preparación previa del paciente, no tienen contraindicación alguna y se completan e informan, según su complejidad, en un período que se extiende entre las dos y las ocho semanas.
A diferencia de la mayoría de los estudios bioquímicos, el test genético se realiza una sola vez en la vida, ya que arrojará siempre el mismo resultado. Esto se debe a que la mayor parte del ADN mantiene su integridad a lo largo de toda nuestra vida y que, salvo ciertas excepciones, no sufrirá cambios.

En pacientes con enfermedades genéticas cuyo diagnóstico es complejo los estudios de paneles de genes y de exoma son de gran importancia. (Sanatorio Allende)
En pacientes con manifestaciones típicas de una determinada enfermedad, el test genético se efectúa para ratificar la existencia de una lesión en dicho gen y confirmar así el diagnóstico de la patología sospechada. En la actualidad, además, es posible analizar en un mismo test un gran conjunto de genes distintos, lo cual posibilita estudiar a pacientes en quienes la manifestación clínica observada es compatible con una lesión en uno de varios genes posibles. Además de estos test genéticos,llamados de “paneles de genes”, hoy es posible realizar un estudio denominado “exoma”, que analiza el conjunto de todos los genes de un individuo en un único test.
La realización de los modernos test genéticos es posible gracias a nuevas tecnologías que permiten “secuenciar” (leer) grandes regiones de ADN en muy poco tiempo.
Si bien esto representa una gran ventaja diagnóstica, los test genéticos pueden aportar datos cuyo efecto en la salud todavía son ignorados. Por ejemplo, estos estudios pueden mostrar alteraciones en ciertos genes que aún se desconoce si pueden ser responsables de una cierta enfermedad. Afortunadamente, la información acumulada a partir de estudios realizados a nivel mundial permite la generación de bases de datos internacionales que posibilitan un reconocimiento más certero de qué variaciones en el ADN son generadoras de problemas de salud.
Sanatorio Allende cuenta con un Servicio de Genética Médica integrado por especialistas en genética clínica que permiten conocer nuestro ADN e información genética. (Sanatorio Allende)
En pacientes con enfermedades genéticas cuyo diagnóstico es complejo y en quienes el estudio secuencial de diferentes genes podría demorar años y tener un costo considerable, los estudios de “paneles de genes” y de “exoma” resultan de gran valor, ya que a través de un único test es posible llegar a un diagnóstico certero sobre una enfermedad.
Además de brindar un diagnóstico preciso en pacientes, los test genéticos pueden ser requeridos por individuos sanos a fin de reconocer la presencia de variaciones en su ADN, que pueden ser eventualmente trasmitidas y causar enfermedad en su descendencia. Uno de los ejemplos más conocidos es el de la fibrosis quística, cuyo estudio genético es llamado screening genético o test de portador. Se realiza en parejas que desean conocer su riesgo de ser portadoras de mutaciones transmisibles a sus hijos. También existen test prenatales que pueden realizarse en mamás en las que se reconoce una anomalía durante el embarazo, o en pacientes con una enfermedad genética familiar heredable, o en mujeres embarazadas de edad avanzada, o en el mismo bebé para conocer si es portador de una afección genética. Muchos de estos test se realizan actualmente a partir de una extracción de sangre a la mamá embarazada, sin existir ningún riesgo para el bebé.
Sanatorio Allende cuenta con un Servicio de Genética Médica integrado por profesionales especializados en genética clínica diagnóstica para el tratamiento y asesoramiento genético familiar. Basados en modernas tecnologías y estrategias de análisis, el Laboratorio de Genética y Biología Molecular ofrece una amplia gama de estudios que permiten conocer nuestro ADN e información genética.
Los médicos especialistas en genética son quienes orientarán al paciente y a su familia en la comprensión de las implicancias médicas relacionadas con la información genética obtenida, razón por la que es fundamental consultar con un profesional idóneo en el tema.